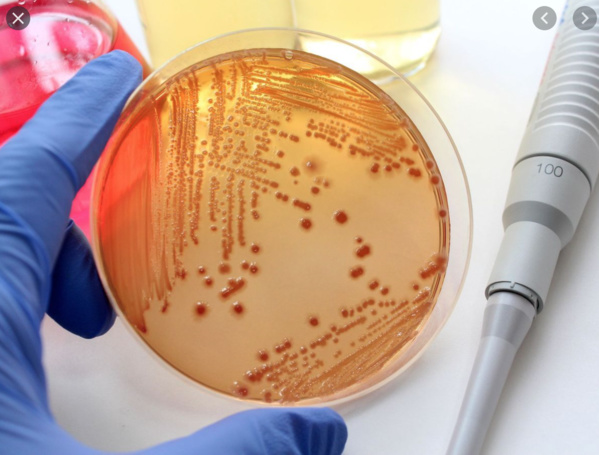
Le ministre de la Santé s’enquiert du déroulement des travaux de construction de l’INRSP Le ministre de la Santé s’enquiert du déroulement des travaux de construction de l’INRSP

Le ministre de la santé, M. Mohamed Nedhirou Hamed, a effectué, mardi matin, en compagnie de l’ambassadeur de la République populaire de Chine, SEM. Li Baijun, une visite d’information sur le déroulement des travaux de construction de l’Institut National de Recherche en Santé Publique (INRSP) dans la moughataa de Riad (Nouakchott-Sud).
Dans une déclaration faite à l’AMI, le ministre a souligné que la visite lui a permis, en compagnie de son SEM. l’ambassadeur de Chine, de s’informer sur le niveau d’avancement des travaux en cours du projet de construction de l’INRSP.
Il a ajouté que cette infrastructure revêt une importance particulière, car elle va permettre une indépendance totale dans la recherche en matière de santé, en particulier dans les domaines des maladies bactériennes, des composants alimentaires et aspects chimiques y afférents.
Il a rappelé que le projet de construction de ce nouvel édifice, dont les travaux seront finalisés dans deux ans, est le fruit d’un don généreux de la République populaire de Chine, louant au passage la très fructueuse et constructive coopération mauritano-chinoise , notamment dans le domaine de la santé.
A son tour, l’ambassadeur de Chine s’est félicité du niveau de la coopération, soulignant que cette coopération se renforce et se développe dans tous les domaines et sur tous les plans.
Il a ajouté que la structure sanitaire en construction va contribuer à l’accès des citoyens aux prestations sanitaires essentielles, indiquant que le projet entre dans le cadre de la coopération bilatérale existant entre les deux pays frères.
Dans une déclaration faite à l’AMI, le ministre a souligné que la visite lui a permis, en compagnie de son SEM. l’ambassadeur de Chine, de s’informer sur le niveau d’avancement des travaux en cours du projet de construction de l’INRSP.
Il a ajouté que cette infrastructure revêt une importance particulière, car elle va permettre une indépendance totale dans la recherche en matière de santé, en particulier dans les domaines des maladies bactériennes, des composants alimentaires et aspects chimiques y afférents.
Il a rappelé que le projet de construction de ce nouvel édifice, dont les travaux seront finalisés dans deux ans, est le fruit d’un don généreux de la République populaire de Chine, louant au passage la très fructueuse et constructive coopération mauritano-chinoise , notamment dans le domaine de la santé.
A son tour, l’ambassadeur de Chine s’est félicité du niveau de la coopération, soulignant que cette coopération se renforce et se développe dans tous les domaines et sur tous les plans.
Il a ajouté que la structure sanitaire en construction va contribuer à l’accès des citoyens aux prestations sanitaires essentielles, indiquant que le projet entre dans le cadre de la coopération bilatérale existant entre les deux pays frères.

Le ministre de la Santé s’enquiert du déroulement des travaux de construction de l’INRSP